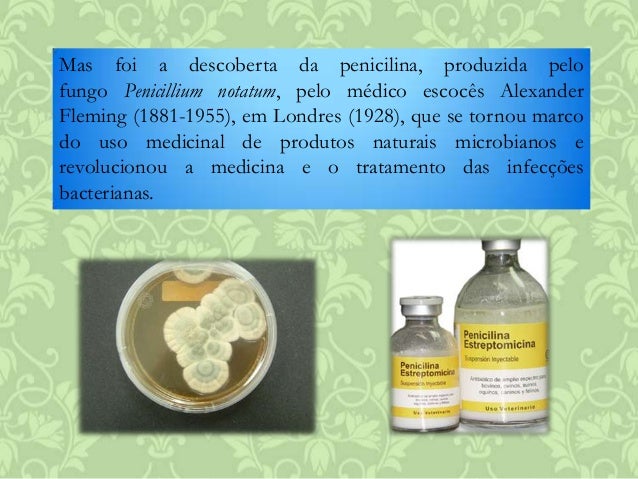

O administrador coleta informações Cite Exemplos Do Uso De Bactérias Na Indústria Farmacêutica.
Https Www Arca Fiocruz Br Bitstream Icict 26200 2 Dayane Santos Pdf

Fonte de :
Importancia Dos Microorganismos Na Medicina

Fonte de : pt.slideshare.net
Gabarito Lista De Exercicios Processos Industriais E Operacoes

Fonte de : docplayer.com.br
Pirogenio E Endotoxina Profes

Fonte de : profes.com.br
Antibioticos Importancia Terapeutica E Perspectivas Para A

Fonte de : dx.doi.org
Microbiologia Resumo O Que E E Microrganismos Toda Materia

Fonte de : www.todamateria.com.br

Aqui está a informação completa sobre cite exemplos do uso de bactérias na indústria farmacêutica. O administrador do blog de Novo Exemplo 02 January 2019 também coleta outras imagens relacionadas ao cite exemplos do uso de bactérias na indústria farmacêutica abaixo.
Bacterias Toda Materia

Fonte de : www.todamateria.com.br
Pdf A Biotecnologia E A Industria Farmaceutica

Fonte de : www.researchgate.net
Riscos Ocupacionais Na Fabricacao De Medicamentos Analise De Uma

Fonte de : www.scielo.br
A Importancia Ecologica Das Bacterias Ecologia Curiosidades

Fonte de : planetabiologia.com
Effect Of Saccharomyces Boulardii Administered In The Feed For 9

Fonte de : www.researchgate.net
Antibioticos Importancia Terapeutica E Perspectivas Para A

Fonte de : www.scielo.br
Os Principios Da Clonagem Molecular Dna Recombinante

Fonte de : kasvi.com.br
Best Em Bacteria Ideas And Get Free Shipping A604

Fonte de : sites.google.com
Staphylococcus Photos And Videos Instabusters Net

Fonte de : instabusters.net
O Que Sao Os Medicamentos Biologicos Ou Biofarmacos Entenda Como

Fonte de : www.ecycle.com.br
Bacterias Microbiologia Biologia Educacao

Fonte de : educacao.globo.com
Pdf O Papel Dos Probioticos E Prebioticos Na Pratica Pediatrica

Fonte de : www.researchgate.net
Essa é a informação que podemos descrever sobre cite exemplos do uso de bactérias na indústria farmacêutica. Obrigado por visitar o blog Novo Exemplo 02 January 2019.